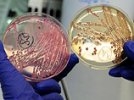
У врачей осталась неделя, чтобы раскрыть секрет бактерии-убийцы - потом будет поздно

У немецких экспертов остается все меньше времени для того, чтобы найти источник смертельно опасной кишечной инфекции, вызвавшей эпидемию в Германии и напугавшей Европу и Россию. Директор экспертной комиссии Всемирной организации здравоохранения (ВОЗ) по инфекционным заболеваниям Гюнель Родье заявил AP, что, если этого не произойдет в недельный срок, причину можно так никогда и не узнать.
Но власти ФРГ выражают оптимизм и утверждают, что самое худшее - пик заболевания - уже позади, хотя и признают, что снимать тревогу пока рано. С таким заявлением перед журналистами выступил во вторник министр здравоохранения страны Даниэль Бахр. В среду он выступал еще более оптимистично, заявив, что число заболевших "значительно снижается", сообщает Reuters.
О постепенном улучшении сообщила и гамбургский сенатор по вопросам здравоохранения Корнелия Прюфер-Шторкс, передает BBC. Некоторые пациенты уже выписаны из больниц, многие идут на поправку, так что появились "проблески надежды", сказала она.
Медики Института имени Роберта Коха - национального центра по контролю над инфекционными заболеваниями - подтвердили, что число вновь заразившихся растет уже не столь стремительно, хотя только во вторник было зарегистрировано 94 новых случая. В Институте при этом затруднились дать прогноз - сохранится ли такая тенденция.
С начала мая, когда в Германии стало известно о первых случаях опасного кишечного заболевания, чреватого тяжелыми осложнениями, отказом почек и смертью, от него погибли 24 человека - 23 в этой стране и один в Швеции. Свыше 2400 человек заразились, из них 100 - в десятке европейских стран и США.
Международные эксперты критикуют Германию за медленную реакцию на болезнь и за то, что они называют "провалами" в расследовании. Один из американских специалистов заявил: "Будь у нас как минимум 200 случаев заболевания, мы бы за 5 дней сумели все прояснить". Действия немецких коллег он расценил как "беспорядочные", а ход расследования в целом назвал "катастрофой".
По мнению зарубежных экспертов, как только началась эпидемия, нужно было собирать как можно больше сведений от самих пациентов. Теперь же, когда овощи практически исчезли с магазинных полок и уличных лотков, обнаружить источник заразы становится все труднее.
Кроме того, власти ФРГ ругают за то, что они спешили во всеуслышание объявлять скороспелые, неподтвержденные выводы. Это создало дополнительные проблемы фермерам, которые и так ежедневно несут колоссальные убытки. Так, например, случилось с испанскими огурцами, в которых подозревали опасный штамм кишечной палочки - как оказалось, напрасно.
В результате Испания и еще ряд стран гневно потребовали от руководства Евросоюза компенсации своим фермерам за нанесенный ущерб. В помощь им обещали выделить 150 миллионов евро, но сами они говорят, что только за неделю теряют до 417 миллионов.
После испанских огурцов подозрения пали на ростки сои с фермы на севере Германии, где отмечено наибольшее число заразившихся, но тесты не позволяют этого подтвердить. На фоне этой неопределенности и паники, охватившей европейцев, стали множиться самые разные гипотезы и слухи - в Чехии на экспертизу отправили свинину и говядину из Германии, другие возложили вину на реакторы, вырабатывающие биогаз из отходов, третьи вообще заговорили о "террористическом заговоре".
Российский эксперт: бактерию несправедливо обозвали мутантом. Как не заразиться Как ранее заявили в ВОЗ, штамм, о котором идет речь, является принципиально новым микроорганизмом, с которым медицина ранее не сталкивалась. Ученые пояснили, что это мутировавшая форма двух различных бактерий кишечной палочки, совмещающая в себе свойства двух возбудителей болезни. На 80% она состоит из привычного штамма и на 20% - из штамма более опасной, супертоксичной бактерии.
Россия, чьи власти запретили ввоз большинства овощей (кроме картофеля) из Евросоюза, присоединится к изучению штамма смертельно опасной бактерии, образец которого получит в ближайшее время.
Александр Подколзин, заведующий лабораторией молекулярной диагностики и эпидемиологии кишечных инфекций московского ЦНИИ эпидемиологии, куда доставят бактерию для изучения, считает, что называть мутантом штамм, гуляющий по Европе, не вполне правомерно.
По его словам, такие возбудители, как энтерогемаррогическая палочка, знакомы ученым давно. Они вызывают заболевания у людей в разных регионах земного шара и каждый возбудитель, выявленный при той или иной новой вспышке, несколько отличается от других, выявленных ранее, цитируют его "Вести".
Российский эксперт рассказал, что заболевание, вызванное новым штаммом, на первом этапе ничем не отличается от банальной диареи. И только спустя некоторое время появляются типичные для него осложнения на почки и анемия.
По его информации, данный патоген уже достаточно хорошо изучен, у российских ученых есть данные, полученные в зарубежных лабораториях. "Мы в настоящее время можем проводить типирование этого патогена - похожи ли изоляты, которые могут быть выявлены на нашей территории, на тот штамм, который циркулирует в Европе", - отметил Подколзин.
Он также дал совет, как избежать заражения. Единственный, по его мнению, способ - это прислушаться к рекомендациям специалистов в Германии и в России, а именно - воздержаться от употребления овощей в регионах, где были зафиксированы вспышки заболевания. Ученый предупредил, что мытье овощей не гарантирует отсутствие в них возбудителей, хотя и снижает риск заражения.
Жители Гамбурга рассказали о болезни и обстановке в городе Между тем "Московский комсомолец" решил получить информацию из первых уст - от тех, кто прошел через болезнь. Журналисты издания дозвонились до жителя Гамбурга, чья дочь была одной из первых заразившихся.
Арндт фон Хоф рассказал, что первым симптомом у дочери Хелены стали сильные боли в животе. Затем появилась тошнота, а вскоре - сильнейшая диарея. Девушку подключили к капельнице. Четыре дня она не пила и не ела, из них три она пролежала в бессознательном состоянии.
По его словам, она ела все те продукты, которые находятся в группе риска, - овощи, в том числе пророщенную сою. Врачи в больнице лечили ее антибиотиками. Сначала намеревались продержать ее не меньше недели, но вскоре стали массово поступать новые пациенты с теми же симптомами, и из-за нехватки мест ее отправили домой раньше.
Фон Хоф также отметил, что врачи вообще очень мало рассказывали о болезни и старались не отвечать на вопросы. Он предполагает, что тем самым они не хотели создавать панику, но эффект, судя по всему, вышел совсем другой. Как узнала газета у других жителей Гамбурга, ситуация в целом очень неспокойная, люди сильно нервничают. Одна женщина, вегетарианка, даже призналась, что у нее случился нервный срыв.
@
NEWS.com